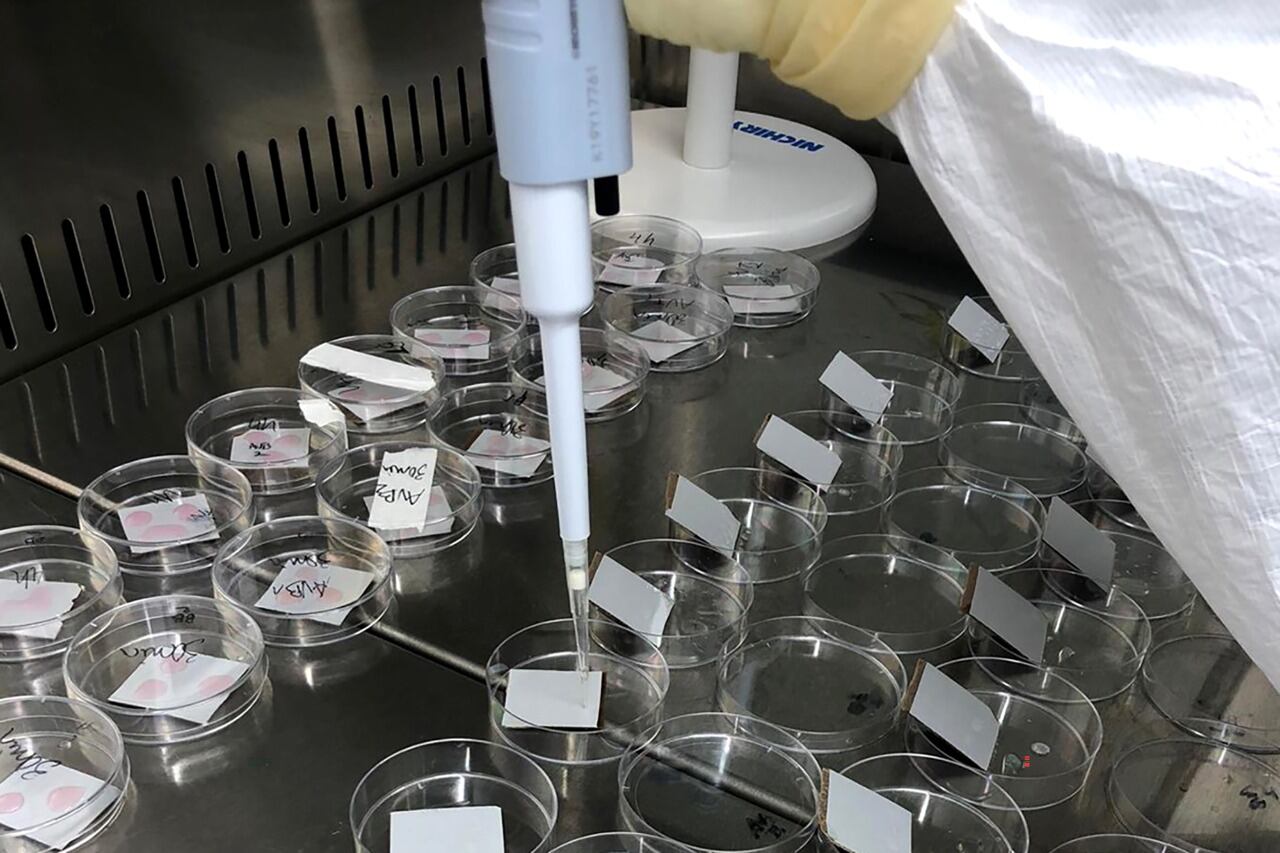
Tiene un "costo de producción mucho más bajo" que las convencionales, lo que las hará "mucho más accesibles para los países pobres".

Se podrá ingerir con yogur o jugo de frutas
Coronavirus: Portugal desarrolla una vacuna oral contra la covid-19
Científicos del Instituto Politécnico de Oporto (IPP), Portugal, están desarrollando una vacuna oral contra el coronavirus que se puede ingerir con líquidos, como el yogur o el jugo de fruta